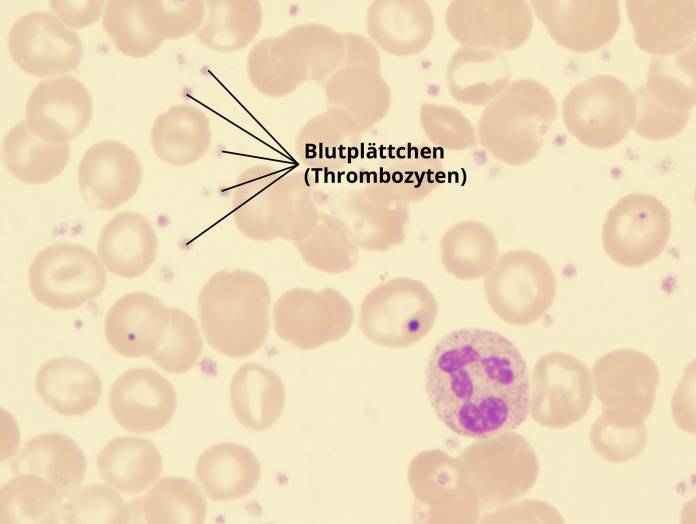

Thrombozyten zu hoch (Thrombozytose)
Die Blutplättchen werden wie die roten Blutkörperchen (Erythrozyten) und die weißen Blutkörperchen (Leukozyten) im Knochenmark gebildet. Ihre Hauptaufgabe ist es, eine Blutung zu stillen. Sie sind wichtig für die Blutgerinnung. Wenn ein Blutgefäß verletzt wird, dann werden die Thrombozyten aktiviert. Sie vernetzen sich (Thrombozytenaggregation) und heften sich an das verletzte Gewebe an (Thrombozytenadhäsion). So kann die Wunde verschlossen und die Blutung gestillt werden.


Sind zu viele Blutplättchen im Blut hat es in den meisten Fällen keine gesundheitlichen Folgen. Manchmal treten Komplikationen auf. Ist die Zahl der Blutplättchen im Blut erhöht, dann nennt der Arzt das Thrombozytose. Ist die Zahl der Blutplättchen im Blut zu niedrig, bezeichnet der Arzt das als Thrombozytopenie oder Thrombopenie.
Der häufigste Grund (80 bis 90 Prozent) einer Thrombozytose ist eine Reaktion auf verschiedene Prozesse im Körper. Diese Art der Thrombozytose wird sekundäre (reaktive) Thrombozytose genannt.
Thrombozyten Normalwerte / Referenzwerte
Bei Frauen und Männern liegt die Zahl der Thrombozyten im Blut bei 150.000 bis 400.000/µl.
| Blutwert | Abkürzung | Männer | Frauen | Weitere Infos |
|---|---|---|---|---|
| Blutplättchen (Thrombozyten) | Thrombos | 150.000 bis 400.000 pro µl | 150.000 bis 400.000 pro µl | zu niedrig |
Höher als die Zahl der Blutplättchen ist die Zahl der roten Blutkörperchen. Pro Mikroliter Blut liegt die Konzentration der roten Blutkörperchen (Erythrozyten) bei Frauen zwischen 4,3 und 5,2 und bei Männern zwischen 4,8 und 5,9 Millionen. Zu den Blutzellen gehören auch die weißen Blutkörperchen (Leukozyten). Sie kommen seltener als Blutplättchen vor. In einem Mikroliter Blut finden sich 4000 bis 10000 Leukozyten.
Ursachen einer Thrombozytose (Thrombozyten zu hoch)
Sekundäre (reaktive) Thrombozytose
Die häufigste Ursache für eine zu hohe Zahl an Blutplättchen im Blut ist die sekundäre (reaktive) Thrombozytose. Die Steigerung der Anzahl der Blutplättchen ist eine Reaktion des Körpers auf bestimmte Ereignisse. Meistens handelt es sich um einen vorübergehenden Anstieg der Zahl der Blutplättchen. Zu den häufigsten Auslösern der sekundären Thrombozytose gehören:
- Infektionen
- chronisch-entzündliche Erkrankungen
- Verletzungen von Gewebe
- einige Formen der Blutarmut (Anämie)

Infektionen, die eine sekundäre (reaktive) Thrombozytose auslösen
Nach einigen Infektionen reagiert unser Körper mit einer Steigerung der Anzahl der Thrombozyten:
- Hirnhautentzündung (Meningitis)
- Lungenentzündung (Pneumonie)
- Gelenkentzündung (septische Arthritis)
- Magen-Darm-Infekt (Gastroenteritis)
- Knochenentzündung (Osteomyelitis)
- Bakterien im Blut (Sepsis)
- Nierenbeckenentzündung (Pyelonephritis)
- Nierenentzündung (Nephritis)
Schwere Infektionen führen zunächst durch einen erhöhten Verbrauch an Blutplättchen zu einem Mangel an Blutplättchen im Blut (Thrombozytopenie). Später erfolgt als Reaktion darauf eine Steigerung der Anzahl der der Blutplättchen im Blut (reaktive Thrombozytose). Dieses Phänomen, das auch als Rebound-Phänomen bekannt ist, kommt auch bei der idiopathischen Thrombozytopenie vor. Das ist eine Autoimmunerkrankung, die sich gegen die körpereigenen Thrombozyten richtet. Das Rebound-Phänomen zeigt sich auch nach einer Chemotherapie.
Chronisch-entzündliche Erkrankungen, die eine sekundäre (reaktive) Thrombozytose auslösen
Wie auch bei den akuten Infektionen, kann die Zahl der Blutplättchen auch bei chronisch-entzündlichen Erkrankungen gesteigert werden. Zu diesen Erkrankungen gehören:
- Rheuma (zum Beispiel Juvenile idiopathische Arthritis)
- Darmerkrankungen (Morbus Crohn, Colitis ulcerosa)
- Gefäßentzündungen (Kawasaki-Syndrom, Purpura Schönlein-Hennoch)
Verletzungen von Gewebe, die eine sekundäre (reaktive) Thrombozytose auslösen
Verletzungen von Gewebe als Folge von Unfällen oder Operationen können zu einer Steigerung der Blutplättchen im Blut führen.
Anämien, die eine sekundäre (reaktive) Thrombozytose auslösen
Erkrankung an roten Blutkörperchen (Erythrozyten) führen dazu, dass der Transport von Sauerstoff im Blut gestört ist. Ein lang anhaltender Sauerstoffmangel kann dazu führen, dass die Anzahl der Blutplättchen im Körper erhöht ist. Bei folgenden Anämien kann eine Thrombozytose auftreten:
- Sichelzellanämie
- Thalassämie (Störung der Hämoglobin-Synthese)
- hämolytische Anämie (verstärkter Abbau von roten Blutkörperchen)
Eine Thrombozytose kann auch bei einer schweren Eisenmangelanämie auftreten. Der Grund dafür ist noch nicht hinreichend geklärt.
Seltene Ursachen für eine sekundäre (reaktive) Thrombozytose
Es gibt einige Erkrankungen, bei denen nicht klar ist, warum die Zahl der Thrombozyten gesteigert ist. Dazu gehören:
- eine Therapie mit Blutverdünnern wie Heparin
- Caffey-Syndrom (eine Skeletterkrankung)
- familiäre Kälteurticaria (eine erbliche Erkrankung mit Fieber, Hautausschlag oder Gelenkschmerzen)
Die Blutplättchen werden unter anderem in der Milz abgebaut. Wird die Milz entfernt, dann ist der Abbau der Blutplättchen verlangsamt und als Reaktion darauf kommt es zu einem starken Anstieg der Blutplättchen im Blut. Die Milz wird zur Behandlung einiger Anämie (Kugelzellanämie, Sichelzellkrankheit) oder nach Unfällen, wenn die Milz betroffen ist, entfernt.
Primäre Thrombozytosen
Primäre Thrombozytosen treten seltener auf. Von primären Thrombozytosen spricht der Arzt, wenn für den Anstieg der Blutplättchen im Blut eine genetische Störung oder eine Störung des Knochenmarks vorliegt. Vererbte Erkrankungen der Thrombozyten werden auch familiäre primäre Thrombozytose genannt. Sie bilden eine Gruppe unterschiedlicher Erkrankungen, die zu einem Anstieg der Blutplättchen im Blut führen. Bösartige Erkrankungen des Knochenmarks, die zu einer Steigerung der Anzahl der Blutplättchen führen, sind:
- myeloproliferative Neoplasien (Gruppe seltener, bösartiger Erkrankungen des Knochenmarks)
- chronisch myeloische Leukämie (Unterform der myeloproliferativen Neoplasien)
Thrombozyten zu hoch – Symptome
Die Neigung der vielen Blutplättchen miteinander zu verklumpen, Blutgerinnsel (Thrombosen) zu bilden und Blutgefäße zu verstopfen, ist das größte Problem von Thrombozytosen.
In den meisten Fällen verursacht die sekundäre (reaktive) Thrombozytose keine Probleme. Die Thrombozytenzahl ist nur geringfügig erhöht. Sie wird oft nur zufällig im Rahmen einer Blutentnahme (kleines Blutbild oder großes Blutbild) entdeckt.
Eine extrem hohe Anzahl an Blutplättchen findet sich vor allem bei primären Thrombozytosen. Bei primären Thrombozytosen kann die Konzentration der Blutplättchen im Blut auf 1 bis 1,5 Millionen pro Mikroliter steigen. Das kann zu erheblichen gesundheitlichen Problemen führen:
- Blutgerinnsel in Blutgefäßen (Thrombosen), die unterschiedliche Gefäße betreffen können (Schlaganfall, Herzinfarkt, Darminfarkt, Beinvenenthrombose)
- ausgeprägte Schleimhautblutungen (Nasenblutung, Schleimhautblutung)
- Blutungen im Magen-Darm-Trakt
- viele blaue Flecken (Hämatome)
- gesteigerter Bauchumfang (erhöhter Abbau von Blutplättchen in der Milz)

Hinweise auf Thrombosen in Hirngefäße können wiederholte Kopfschmerzen sein. Wer an einer primären Thrombozytose leidet, sollte die Anti-Baby-Pille und das Rauchen vermeiden. Diese führen zu einem gesteigerten Thromboserisiko. Übergewicht, Schwangerschaft, ein Mangel an Flüssigkeit und starke körperliche Anstrengung sind weitere Faktoren, die zu einem gesteigerten Thromboserisiko führe.
Was tut der Arzt bei einer Thrombozytose?
Die Abklärung einer Thrombozytose beinhaltet ein ausführliches Gespräch mit dem Arzt und eine körperliche Untersuchung des Patienten. Zur Verlaufskontrolle wird regelmäßig Blut entnommen und die Entzündungsparameter bestimmt. Bei sekundären Thrombozytosen sind die Entzündungsparameter in der Regel verändert, bei primären meistens normal. Geht der Arzt von einem Entzündungsherd aus, dann wird er zur Suche nach dem Herd Ultraschall- und Röntgenuntersuchungen veranlassen. Besteht der Verdacht auf eine primäre Thrombozytose, dann wird eine Knochenmarksbiopsie durchgeführt, um diese festzustellen. Bei sekundären Thrombozytosen ist in der Regel keine Behandlung erforderlich. Nur wenn andere Faktoren dazu führen, dass das Risiko für die Bildung von Blutgerinnsel erhöht ist, müssen vorbeugend gerinnungshemmende Medikamente eingenommen werden.
aktualisiert am 06.09.2023



